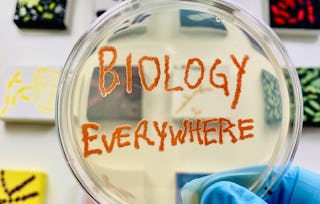

In this course, we will explore the nature of science and biology. We will discuss what the “biology everywhere” philosophy means and the history of the “biology everywhere” project. We will also discuss what science (and biology) are as a discipline of inquiry and how chemistry is foundational to understanding biology.

Biology Everywhere Foundations

Biology Everywhere Foundations
This course is part of Biology Everywhere Specialization

Instructor: Melanie Peffer
Access provided by CalArts
18,221 already enrolled
239 reviews
What you'll learn
Describe the biology everywhere philosophy.
Explain how the process of science works and identify common misconceptions.
Explain and critique the criteria for identifying living and non-living entities.
Explain the relationship between chemistry and biology.
Skills you'll gain
Details to know

Add to your LinkedIn profile
See how employees at top companies are mastering in-demand skills

Build your subject-matter expertise
- Learn new concepts from industry experts
- Gain a foundational understanding of a subject or tool
- Develop job-relevant skills with hands-on projects
- Earn a shareable career certificate

There are 4 modules in this course
In this module, we'll explore the principles behind biology everywhere and Dr. Peffer's motivation for writing Biology Everywhere: How the science of life matters to everyday life, including the creation of this specialization.
What's included
4 videos5 readings2 peer reviews1 discussion prompt2 plugins
In this module, we'll discuss the foundations of what science is (and isn't).
What's included
1 video1 assignment2 peer reviews1 plugin
In this module we'll discuss what it means to be alive.
What's included
1 video1 assignment
Chemistry is foundational to understanding biology. In this module, we'll explore the chemical basis of biology.
What's included
2 videos2 readings1 assignment2 peer reviews
Earn a career certificate
Add this credential to your LinkedIn profile, resume, or CV. Share it on social media and in your performance review.
Instructor

Offered by
Why people choose Coursera for their career

Felipe M.

Jennifer J.

Larry W.

Chaitanya A.
Learner reviews
- 5 stars
73.22%
- 4 stars
16.73%
- 3 stars
3.76%
- 2 stars
2.09%
- 1 star
4.18%
Showing 3 of 239
Reviewed on Oct 19, 2020
Informative and easy to follow. Thank you very much!
Reviewed on Sep 27, 2024
In this course, all the videos and readings were very helpful to complete the assignments. Thank you!
Reviewed on May 16, 2022
I enjoyed this course a lot! It showed me a different way of viewing the sciences.
Explore more from Health
University of Colorado Boulder

University of Colorado Boulder

University of North Texas

Birla Institute of Technology & Science, Pilani
¹ Some assignments in this course are AI-graded. For these assignments, your data will be used in accordance with Coursera's Privacy Notice.

